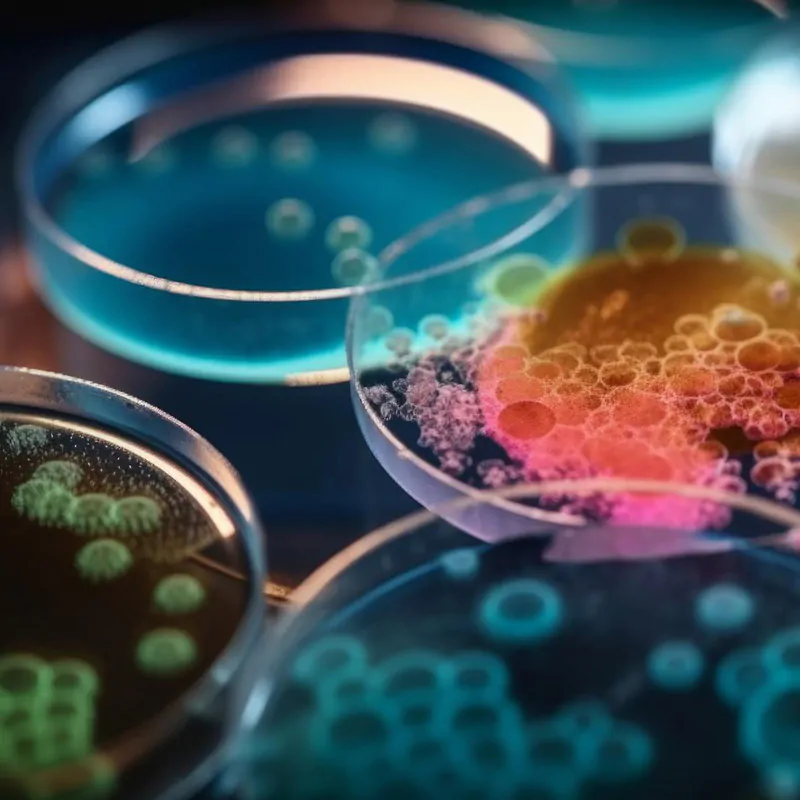
microbiological-01
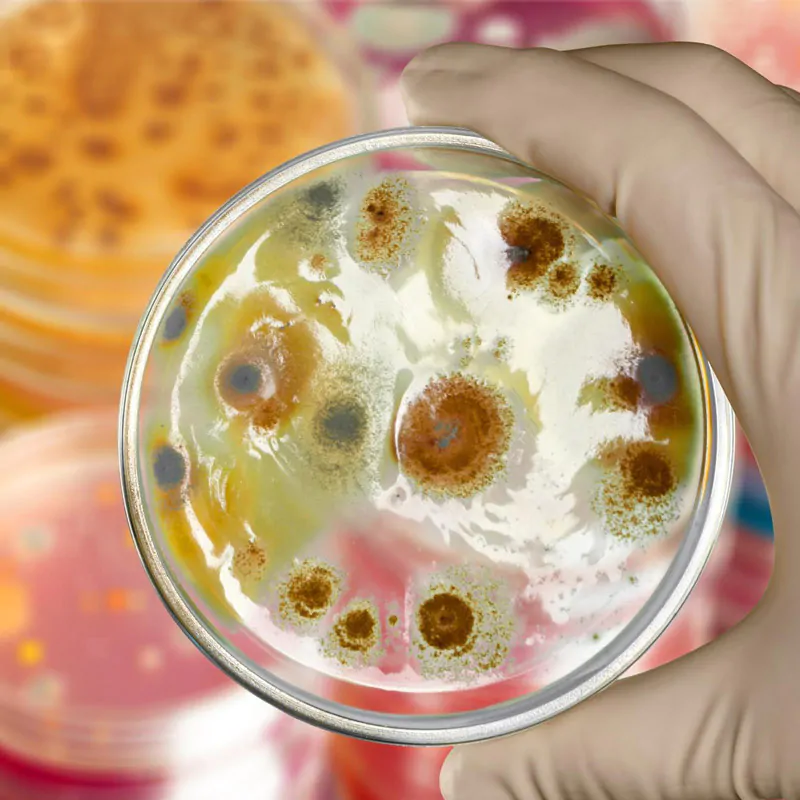
Microbiological Media And Supplement

Microbiological Media & Supplement

Microbiological Media & Supplement
All sorts of microbiological media types are carefully selected and compounded to meet the different requirements of modern laboratories involved in microbiology. Ranging from simple to sophisticated microbial analyses, we have solutions to most needs. Indeed, from preparing high-quality dehydrated media for custom preparations up to providing ready-to-use, easy-to-use media for fast testing solutions, our products fit well within the processes of laboratory work.
Having the record of being a top-rated medical laboratory equipment supplier in Warszawa, Poland, we ensure that every product reaching your laboratory is of international standards so that you get reliable, accurate results from your lab. Let Polskie Laboratium & Lab Supplies ensure that you get top-grade microbiological media and a comprehensive lab solution to enhance the capabilities of your microbiology laboratory in the Warszawa, Poland.
Enquire Now



Microbiological Media & Supplements by Polskie Laboratium
At Polskie Laboratium, with the highest concentrations, our products and services meet the diverse needs of institutes and laboratories in the Warszawa, Poland. With our substantial product range, a full range of supplies ensures that you have every tool on hand to carry out microbiological analysis accurately and efficiently.
Comprehensive Range of Microbiological Media
The product line we offer includes a wide selection of microbiological media, meticulously formulated to provide the environment needed for the growth and identification of an enormous variety of microorganisms. All our media solutions are produced to give reliable results, no matter whether you’re carrying out clinical diagnostics, environmental monitoring, or food and beverage testing. Take a look at our range of agar plates, broths, and special media suited to particular applications.



Premium-quality Quality Supplements
Apart from our assortment of microbiological media, we also offer various specialized supplements specifically designed to enhance the efficiency and specificity of the culture media. These supplements are formulated to enrich microbiological media with essential nutrients and growth factors perfect for the procreation of microorganisms. This leads to quicker and more dependable results for microbial research and diagnostics.
Tailored Solutions for Diverse Applications
Polskie Laboratium understands that different applications call for different media and supplements, and its tailor-makes a special solution to meet your needs. Our team of professionals is always at your service in your efforts to make the best choices. Whether you are working with bacteria, fungi, or other microorganisms, we tailor our solutions to help you achieve your goals in research and diagnosis.
Commitment to Excellence
Our commitment to quality does not stop with the best products. We want to assure that all our customers receive advantageous guidance and information. Once you have our products in your hands, we are always ready to help you. Our trained, well-informed staff is always available around the clock to answer your questions and offer technical assistance.
FAQ
What are microbiological media?
What is Microbiological Media? Microbiological or bacterial culture media is a growth medium used to grow bacteria. In other words, it contains everything bacteria need to grow outside the body and under laboratory conditions
What are the 3 types of media used in a microbiology lab?
The three common forms of media used by microbiologists are nutritional, selective, and differential. Nutritional media such as Tripsicase Soy Agar is used to observe colony morphology and to obtain growth of the organism for further testing.
What are microbiological products?
Microbial products are products derived from various microscopic organisms. Microbial products may consist of the organisms themselves and/or the metabolites they produce.
Can I reuse microbiological media?
Generally, microbiological media are not reusable. Once they have been used,they may be contaminated ordepleted of nutrients and should be properly disposed of.
What role do microbiological media play in industrial applications?
In industries like pharmaceuticals, food, and biotechnology, microbiological media are used for product development, quality control, and large scale production of microbial products like antibiotics, enzymes, and fermented foods.



